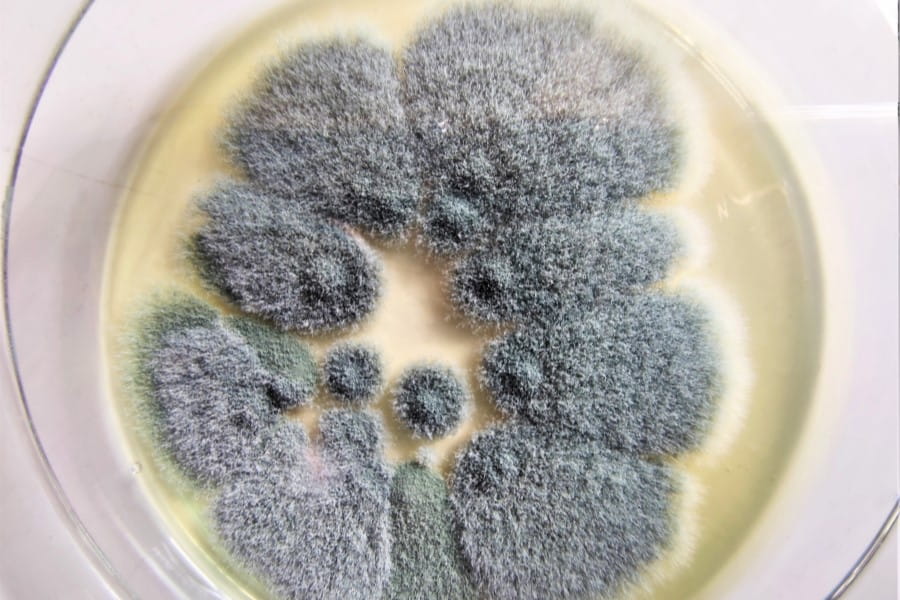

Aspergiloza – przyczyny, objawy, diagnostyka, leczenie
- Publikacja:
- 2022-02-08 11:55
- Aktualizacja:
- 2025-06-03 14:20
Aspergiloza jest najcięższą postacią zakażenia układu oddechowego przez grzyby z rodzaju Aspergillus. U około 50% pacjentów grzyb rozsiewa się do innych narządów: mózgu, wątroby, nerek oraz układu pokarmowego. Jakie są przyczyny i objawy aspergilozy? Jak przebiega diagnostyka oraz leczenie tej choroby?
Jakie są rodzaje aspergilozy?
W zależności od miejsca zaatakowania grzyba wyróżniamy kilka rodzajów aspergilozy do których należy:
- Alergiczna aspergiloza oskrzelowo-płucna, która powoduje zapalenie płuc.
- Alergiczne zapalenie zatok.
- Oporny na leczenie Aspergillus fumigatus, dzięki oporności na leki jest ciężki do zwalczenia.
- Aspergilloma atakuje płuca oraz zatoki, lecz nie rozprzestrzenia się na pozostałe części ciała.
- Przewlekła aspergiloza płuc – może powodować długotrwałe ubytki w płucach.
- Aspergiloza inwazyjna występuje, gdy grzyb powoduje poważne infekcje i zwykle dotyczy osób z upośledzonym układem immunologicznym. Postać ta najczęściej atakuje płuca, ale może również rozprzestrzenić się na inne części ciała.
- Aspergiloza skórna występuje, gdy grzyb dostanie się do organizmu przez ranę skóry.
Najczęstsze przyczyny aspergilozy
Aspergiloza inaczej zwana grzybicą kropidlakową jest chorobą wywołaną przez patogeny należące do rodzaju Aspergillus. Najczęstszym gatunkiem wywołującym zakażenie jest Aspergillus fumigatus.
Do czynników sprzyjających rozwojowi tej choroby należy:
- terapia lekami immunosupresyjnymi i cytostatykami;
- przeszczepy narządów;
- choroby rozrostowe układu krwiotwórczego;
- AIDS;
- choroby alergiczne;
- mukowiscydoza.
Aspergiloza inwazyjna najczęściej rozwija się u chorych z zaawansowanymi nowotworami, w trakcie chemioterapii oraz u osób z ciężkimi i długotrwałymi zaburzeniami odporności.
Jak objawia się aspergiloza?
Najczęstsze objawy inwazyjnej aspergilozy to:
- gorączka;
- ból opłucnowy;
- krwioplucie;
- kaszel i duszności;
- owrzodzenia skóry;
- trudności widzenia;
- zakażenia ucha zewnętrznego.
Makrofagi pęcherzykowe znajdujące się w płucach stanowią pierwszą linię obrony przed wziewnymi konidiami grzybów z rodzaju Aspergillus. W płucach znajdują się receptory rozpoznania patogenu, które identyfikują specyficzne składniki ściany grzybowej i produkują cytokiny, stymulujące mechanizm obronny przeciwko strzępkom Aspergillus.
Aspergiloza - diagnostyka
W badaniu RTG dostrzegane są zmiany przypominające odoskrzelowe zapalenie płuc lub pojedyncze zacienienia. W badaniu TK (tomografia komputerowa) charakterystyczne są centralnie położone zacienienia odpowiadające martwicy skrzepowej. Istnieją trzy stopnie rozpoznania wystąpienia aspergilozy. Pewnym dowodem na zakażenie grzybicą kropidlakową jest stwierdzenie strzępek grzyba w materiale tkankowym lub wyhodowanie go z materiału tkankowego. W celu wczesnego rozpoznania wykorzystuje się metody immunologiczne, metaboliczne i genetyczne. Metody, w których oznacza się przeciwciała przeciwgrzybiczne, mają niską czułość u osób stosujących immunosupresję. Ostatnią metodą wczesnej identyfikacji grzybów jest oznaczenie genomu kropidlaka za pomocą łańcuchowej reakcji polimerazy w materiale z popłuczyn oskrzelikowo-pęcherzykowych i we krwi.
Metody leczenia aspergilozy
Warunkiem skutecznego leczenia inwazyjnej aspergilozy płuc jest poprawa lub przywrócenie prawidłowego funkcjonowania układu odpornościowego. Wraz z leczeniem farmakologicznym warto wprowadzić odpowiednio zbilansowana dietę zwiększającą odporność organizmu. W miesiącach od września do kwietnia zalecana jest suplementacja witaminy D, ponieważ jej synteza skórna nie jest wystarczająca. Warto wykonać badanie określające poziom witaminy D w organizmie i na tej podstawie po konsultacji lekarskiej wspomóc się preparatami dostępnymi w aptece, np.: Vigantoletten Max, Witamina D3 Forte Myvita, Vitagal Witamina D3, D-Vitum Forte.
Dostępność tych oraz wielu innych preparatów w aptekach w Twojej okolicy możesz sprawdzić za pomocą portalu KtoMaLek.pl.
Stosowane jest także wielotygodniowe leczenie przeciwgrzybicze, a także leczenie chirurgiczne zmian. Standardowa antybiotykoterapia powinna trwać 10-12 tygodni. Lekami o największej skuteczności są amfoterycyna i azole. W mikrobiologicznie potwierdzonej aspergilozie płuc lekiem pierwszego wyboru jest worikonazol, a w niepotwierdzonej – amfoterycyna. W większości przypadków stosuje się monoterapię. W postępującej infekcji i postaci rozsianej aspergilozy uzasadnione może być zastosowanie kombinacji leków jako terapii ratunkowej.
Narażenie na grzyby nie zawsze powoduje wystąpienie aspergilozy. Większość ludzi wdycha zarodniki grzybów każdego dnia, jednocześnie nie wykazując objawów chorobowych. Największe ryzyko infekcji występuje u osób z osłabionym układem odpornościowym lub chorobą płuc.
Autor
Redakcja ktomalek.pl - Zespół redakcyjny KtoMaLek.pl tworzą doświadczeni farmaceuci, którzy specjalizują się w różnych obszarach tematyki zdrowotnej. Doświadczenie zdobyte w zawodzie oraz wiedza uzyskana podczas studiów farmaceutycznych, pozwalają na tworzenie merytorycznych treści zgodnych z EBM (and. Evidence-based Medicine), opartych na rzetelnych źródłach — aktualnych badaniach naukowych, branżowych podręcznikach i książkach. Za praktyką podążają również pasja i niesłabnąca chęć do poszerzania wiedzy oraz dzielenia się nią z pacjentami. Dzięki temu użytkownicy otrzymują dostęp do ciekawych i angażujących materiałów edukacyjnych.